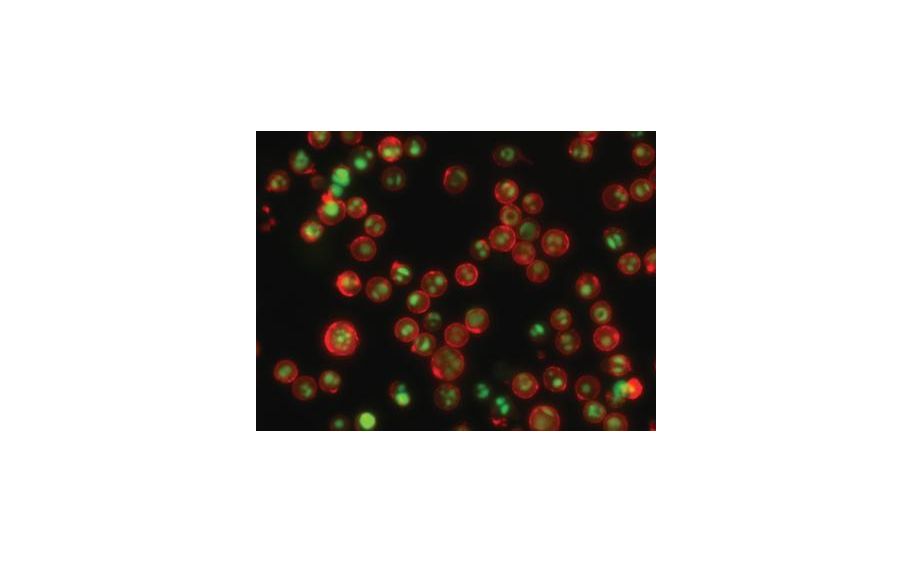
main product photo

Need Help?
800-229-7252

KIT NUCVIEW488-MITOVIEW633 APOP 100ASS
1
/
EA
Lead Time
12 Day(s)
SKU
VWR89411-556-EA
MFRPN
30062
Nucview488-Mitoview633 Kit This kit contains green fluorescent NucView 488 Caspase 3 substrate for detecting caspase-3 activity in intact cells and far red fluorescent MitoView 633 for measuring mitochondrial membrane potential.
| Manufacturer | Biotium |
|---|---|
| MFRPN | 30062 |
| Lead Time | 12 Day(s) |
| UNSPSC Code | 12000000 |
Write Your Own Review